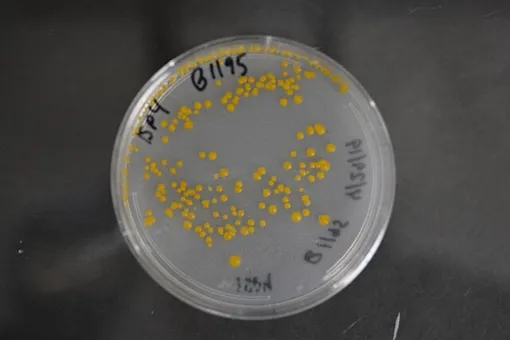
Антибиотик Streptomyces fradiae Антибиотик стрептомицин

Антибиотики из почвы: как Зельман Ваксман нашел лекарство от туберкулеза

- Дата рождения22 Июля 1888
- Род деятельностиученый, биохимик, биолог, химик, преподаватель
- Страна рожденияУкраина
- Дата смерти16 Августа 1973
- ПолМужской
- ОбразованиеУниверситет Рутгерса, Калифорнийский университет в Беркли
- В браке сДебора Б. Митник
- РодителиЯков Ваксман и Фредия Лондон
- ДетиБайрон Х. Ваксман
- Полное имяЗельман Ваксман
В начале XX века туберкулез уносил жизни сотен людей ежедневно. Врачи были бессильны перед болезнью. Все изменилось, когда в 1943 году Зельман Ваксман выделил из почвы стрептомицин — первое эффективное лекарство от туберкулеза.
Первый шаги Зельмана Ваксмана в науке
Зельман Ваксман родился в еврейской семье. Мальчика воспитывали в традициях народа — в 13 лет он прошел обряд бар-мицвы, символизирующий совершеннолетие.
Сначала Зельман получал образование у частных репетиторов, а затем выучился в вечерней школе в Одессе. В 1910 году он с отличием окончил Пятую одесскую гимназию, получил аттестат зрелости. В том же году умерла его мать, и Ваксманы переехали жить в США.
В 1911 году Зельман поступил в Рутгерский колледж, ныне университет, в Нью-Джерси. Тогда у юноши не было никакой финансовой поддержки от семьи, и он жил на стипендию и случайный заработок. Так, он работал ночным сторожем, воскресным смотрителем, репетитором по английскому языку и научным дисциплинам. Сам же он проявлял интерес к естественным наукам.
В 1915 году Ваксман получил степень бакалавра в области сельского хозяйства, а год спустя — степень магистра естественных наук. Уже в студенческие годы он начал проводить исследования в области почвенной бактериологии под руководством своего декана Джейкоба Г. Липмана.
Спустя еще два года Зельман защитил докторскую диссертацию по биохимии в Калифорнийском университете в Беркли, после чего вернулся в Ратгерс уже в качестве преподавателя.
От почвенных микробов к антибиотикам
В 1918 году Зельман был назначен лектором по микробиологии почвы в Ратгерском университете, а параллельно с этим работал в качестве микробиолога на сельскохозяйственной экспериментальной станции Липмана. Его первые исследования касались актиномицетов — группы почвенных бактерий — и микроорганизмов, участвующих в окислении серы. Тогда же он выделил бактерии Thiobacillus thiooxidans.
Спустя шесть лет ученый совершил поездку в Европу, где принял участие в Международной конференции по почвоведению в Риме и посетил крупнейшие микробиологические станции. По возвращении он опубликовал работу «Микробиология почвы», а после «Принципы микробиологии почвы».
К 1930-м годам Ваксман стал признанным ученым в области почвенных микробов. Он разработал стандартизированные методы оценки микробных популяций в почве и изучил процессы разложения органических остатков и формирования гумуса.
А в 1931 году он организовал лабораторию по изучению морской микробиологии, где в течение 12 лет исследовал проблемы обрастания судов и защиты материалов от биоповреждений.
Открытие антибиотиков и борьба с туберкулезом
В 1939 году Ваксман изучал почвенные микроорганизмы, способные производить вещества с антимикробными свойствами. Именно он ввел понятие «антибиотик» для обозначения таких веществ.
Его команда изучила более тысячи образцов почвы. В результате в 1943 году они открыли стрептомицин — первый эффективный противотуберкулезный антибиотик.
Клинические испытания, проведенные в сотрудничестве с клиникой Майо, подтвердили эффективность и безопасности стрептомицина, и к началу 1950-х годов смертность от туберкулеза снизилась во всем мире.
Кроме того, под руководством Ваксмана было открыто около 20 антибиотиков, включая актиномицин — используют в терапии некоторых онкологических заболеваний — и неомицин — применяют для лечения инфекций и воспалений в разных частях тела.
В 1952 году Зельман был удостоен Нобелевской премии по физиологии и медицине «за открытие стрептомицина — первого антибиотика, эффективного при лечении туберкулеза».
На гонорары от открытий в 1954 году Ваксман основал Институт микробиологии при Ратгерском университете, который с 1974 года носит имя ученого. Сейчас он считается мировым центром микробиологии. Там проводят исследования в области молекулярной генетики микроорганизмов, развития и растений, а также структурной и вычислительной биологии.
Премии
- 1952 Нобелевская премия по физиологии и медицине
- 1950 Медаль Левенгука
- 1948 Премия Альберта Ласкера за фундаментальные медицинские исследования